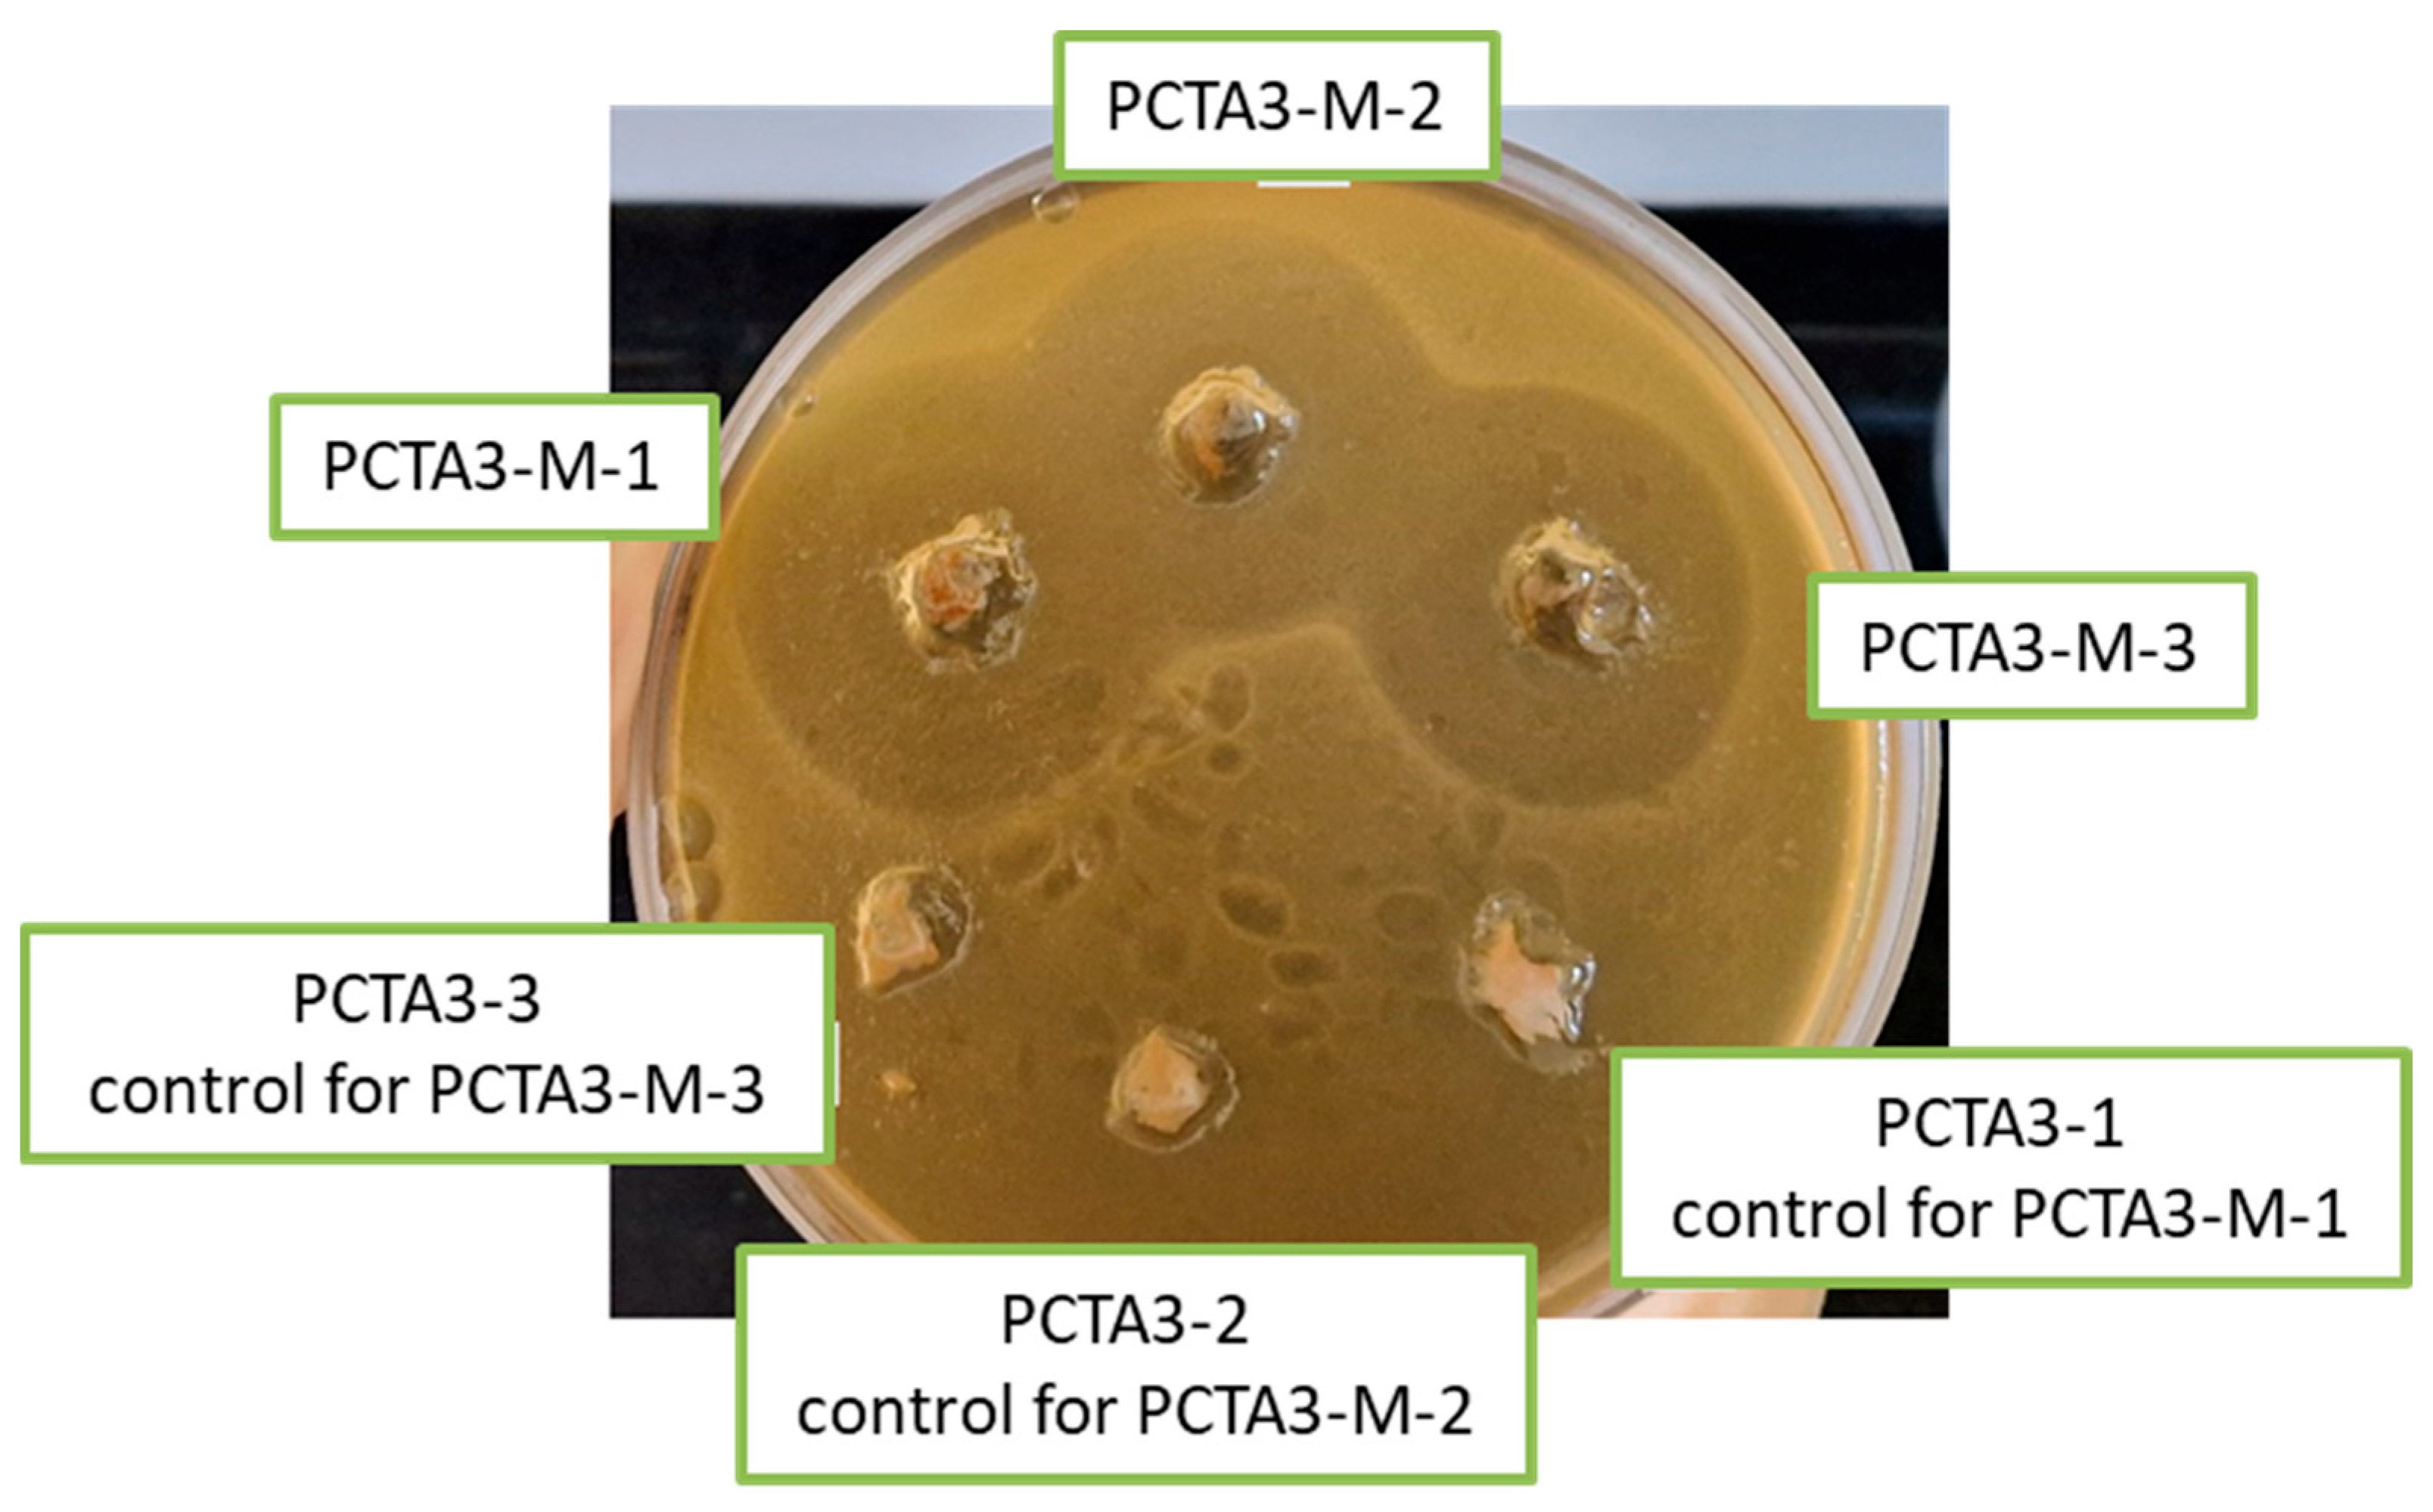
Pharmaceutics 17 00294 g009

Metronidazole-Loaded Chitosan Nanoparticles with Antimicrobial Activity Against Clostridium perfringens
Abstract
1. Introduction
2. Materials and Methods
2.1. Materials
2.2. Preparation Method
2.3. Nanoparticles Characterization
2.3.1. FTIR Analysis
2.3.2. Morphology of Nanoparticles
2.3.3. Swelling Behavior
2.3.4. Drug Loading and In Vitro Release of Metronidazole
2.3.5. In Vitro Hemolysis Tests
2.3.6. Cytotoxicity Tests
2.3.7. The Antimicrobial Activity
3. Results and Discussion
3.1. FTIR Analysis
3.2. Morphological Characteristics
3.3. Swelling Studies
3.4. Drug Loading and In Vitro Release of Metronidazole
3.5. In Vitro Hemolysis Tests
3.6. Cytotoxicity Tests
3.7. The Antimicrobial Activity
4. Conclusions
Supplementary Materials
Author Contributions
Funding
Institutional Review Board Statement
Informed Consent Statement
Data Availability Statement
Conflicts of Interest
References
- Khandia, R.; Puranik, N.; Bhargava, D.; Lodhi, N.; Gautam, B.; Dhama, K. Wound Infection with Multi-Drug Resistant Clostridium perfringens: A Case Study. Arch. Razi Inst. 2021, 76, 1565–1573. [Google Scholar]
- Yang, C.C.; Hsu, P.C.; Chang, H.J.; Cheng, C.W.; Lee, M.H. Clinical significance and outcomes of Clostridium perfringens bacteremia--a 10-year experience at a tertiary care hospital. Int. J. Infect. Dis. 2013, 17, e955–e960. [Google Scholar] [CrossRef] [PubMed]
- Preseau, T.; Deviendt, J.; Duttman, R.; Attou, R.; Franck, D.; Claeys, R.; Honoré, P.M.; De Bels, D. Clostridium perfringens in Gas Gangrene: Still a Smoked Gun! J. Transl. Int. Med. 2020, 8, 54–56. [Google Scholar] [CrossRef]
- Galoyan, A.A. Treatment of Clostridium perfringens-induced Gas Gangrene by New Cytokines of Brain. In Brain Immune System Signal Molecules in Protection from Aerobic and Anaerobic Infections. Advances in Neurobiology; Springer: New York, NY, USA, 2012; Volume 6, pp. 103–119. [Google Scholar]
- Löfmark, S.; Edlund, C.; Nord, C.E. Metronidazole is still the drug of choice for treatment of anaerobic infections. Clin. Infect. Dis. 2010, 50 (Suppl. S1), S16–S23. [Google Scholar] [CrossRef] [PubMed]
- Nandhini, J.; Karthikeyan, E.; Rajeshkumar, S. Nanomaterials for wound healing: Current status and futuristic frontier. Biomed. Technol. 2024, 6, 24–45. [Google Scholar] [CrossRef]
- Gowda, B.H.J.; Mohanto, S.; Singh, A.; Bhunia, A.; Abdelgawad, M.A.; Ghosh, S.; Ansari, M.J.; Pramanik, S. Nanoparticle-based therapeutic approaches for wound healing: A review of the state-of-the-art. Mater. Today Chem. 2023, 27, 101319. [Google Scholar] [CrossRef]
- Sreeharsha, N.; Rajpoot, K.; Tekade, M.; Kalyane, D.; Nair, A.B.; Venugopala, K.N.; Tekade, R.K. Development of Metronidazole Loaded Chitosan Nanoparticles Using QbD Approach-A Novel and Potential Antibacterial Formulation. Pharmaceutics 2020, 12, 920. [Google Scholar] [CrossRef]
- Kuznetsova, D.A.; Gabdrakhmanov, D.R.; Lukashenko, S.S.; Ahtamyanova, L.R.; Nizameev, I.R.; Kadirov, M.K.; Zakharova, L.Y. Novel hybrid liposomal formulations based on imidazolium-containing amphiphiles for drug encapsulation. Colloids Surf. B 2019, 178, 352–357. [Google Scholar] [CrossRef]
- Andersen, T.; Vanić, Ž.; Flaten, G.E.; Mattsson, S.; Tho, I.; Škalko-Basnet, N. Pectosomes and Chitosomes as Delivery Systems for Metronidazole: The One-Pot Preparation Method. Pharmaceutics 2013, 5, 445–456. [Google Scholar] [CrossRef]
- Sánchez, A.; Mejía, S.P.; Orozco, J. Recent Advances in Polymeric Nanoparticle-Encapsulated Drugs against Intracellular Infections. Molecules 2020, 25, 3760. [Google Scholar] [CrossRef]
- Cadinoiu, A.N.; Peptu, C.A.; Fache, B.; Chailan, J.F.; Popa, M. Microparticulated systems based on chitosan and poly(vinyl alcohol) with potential ophthalmic applications. J. Microencapsul. 2015, 32, 381–389. [Google Scholar] [CrossRef] [PubMed]
- Jătariu Cadinoiu, A.N.; Holban, M.N.; Peptu, C.A.; Sava, A.; Costuleanu, M.; Popa, M. Double crosslinked interpenetrated network in nanoparticle form for drug targeting--preparation, characterization and biodistribution studies. Int. J. Pharm. 2012, 436, 66–74. [Google Scholar] [CrossRef] [PubMed]
- Ramos, J.; Forcada, J.; Hidalgo-Alvarez, R. Cationic polymer nanoparticles and nanogels: From synthesis to biotechnological applications. Chem. Rev. 2014, 114, 367–428. [Google Scholar] [CrossRef] [PubMed]
- Ibezim, E.C.; Andrade, C.T.; Marcia, C.; Barretto, B.; Odimegwu, D.C.; De Lima, F.F. Ionically Cross-linked Chitosan/Tripolyphosphate Microparticles for the Controlled Delivery of Pyrimethamine. Ibnosina J. Med. Biomed. Sci. 2011, 3, 77–88. [Google Scholar] [CrossRef]
- Garg, U.; Chauhan, S.; Nagaich, U.; Jain, N. Current Advances in Chitosan Nanoparticles Based Drug Delivery and Targeting. Adv. Pharm. Bull. 2019, 9, 195–204. [Google Scholar] [CrossRef]
- Ghadi, A.; Mahjoub, S.; Tabandeh, F.; Talebnia, F. Synthesis and optimization of chitosan nanoparticles: Potential applications in nanomedicine and biomedical engineering. Casp. J. Intern. Med. 2014, 5, 156–161. [Google Scholar]
- Sangnim, T.; Dheer, D.; Jangra, N.; Huanbutta, K.; Puri, V.; Sharma, A. Chitosan in Oral Drug Delivery Formulations: A Review. Pharmaceutics 2023, 15, 2361. [Google Scholar] [CrossRef]
- Li, J.; Cai, C.; Li, J.; Li, J.; Li, J.; Sun, T.; Wang, L.; Wu, H.; Yu, G. Chitosan-Based Nanomaterials for Drug Delivery. Molecules 2018, 23, 2661. [Google Scholar] [CrossRef]
- Rivero, S.; García, M.A.; Pinotti, A. Crosslinking capacity of tannic acid in plasticized chitosan films. Carbohydr. Polym. 2010, 82, 270–276. [Google Scholar] [CrossRef]
- Wang, C.; Chen, P.X.; Xiao, Q.; Yang, Q.M.; Weng, H.F.; Zhang, Y.H.; Xiao, A.F. Chitosan Activated with Genipin: A Nontoxic Natural Carrier for Tannase Immobilization and Its Application in Enhancing Biological Activities of Tea Extract. Mar. Drugs 2021, 19, 166. [Google Scholar] [CrossRef]
- Qin, Z.; Huang, Y.; Xiao, S.; Zhang, H.; Lu, Y.; Xu, K. Preparation and Characterization of High Mechanical Strength Chitosan/Oxidized Tannic Acid Composite Film with Schiff Base and Hydrogen Bond Crosslinking. Int. J. Mol. Sci. 2022, 23, 9284. [Google Scholar] [CrossRef]
- Cheng, M.; Hu, L.; Xu, G.; Pan, P.; Liu, Q.; Zhang, Z.; He, Z.; Wang, C.; Liu, M.; Chen, L.; et al. Tannic acid-based dual-network homogeneous hydrogel with antimicrobial and pro-healing properties for infected wound healing. Colloids Surf. B 2023, 227, 113354. [Google Scholar] [CrossRef] [PubMed]
- Youness, R.A.; Kamel, R.; Elkasabgy, N.A.; Shao, P.; Farag, M.A. Recent Advances in Tannic Acid (Gallotannin) Anticancer Activities and Drug Delivery Systems for Efficacy Improvement; A Comprehensive Review. Molecules 2021, 26, 1486. [Google Scholar] [CrossRef]
- Ahmad, T. Reviewing the Tannic Acid Mediated Synthesis of Metal Nanoparticles. J. Nanotechnol. 2014, 2014, 954206. [Google Scholar] [CrossRef]
- Pucci, C.; Martinelli, C.; De Pasquale, D.; Battaglini, M.; di Leo, N.; Degl'Innocenti, A.; Belenli Gümüş, M.; Drago, F.; Ciofani, G. Tannic Acid-Iron Complex-Based Nanoparticles as a Novel Tool against Oxidative Stress. ACS Appl. Mater. Interfaces 2022, 14, 15927–15941. [Google Scholar] [CrossRef] [PubMed]
- Popa, M.; Ciobanu, B.C.; Ochiuz, L.; Desbrieres, J.; Stan, C.S.; Peptu, C.A. Controlling the release kinetics of calcein loaded liposomes from chitosan/tannic acid and chitosan/poly(vinyl alcohol)/tannic acid hydrogels. Cellul. Chem. Technol. 2018, 52, 353–370. [Google Scholar]
- Marques, M.R.C.; Loebenberg, R.; Almukainzi, M. Simulated biological fluids with possible application in dissolution testing. Dissolut. Technol. 2011, 18, 15–28. [Google Scholar] [CrossRef]
- Di Santo, M.C.; D' Antoni, C.L.; Domínguez Rubio, A.P.; Alaimo, A.; Pérez, O.E. Chitosan-tripolyphosphate nanoparticles designed to encapsulate polyphenolic compounds for biomedical and pharmaceutical applications—A review. Biomed. Pharmacother. 2021, 142, 111970. [Google Scholar] [CrossRef]
- Rață, D.M.; Cadinoiu, A.N.; Atanase, L.I.; Calin, G.; Popa, M. Design and characterization of dexamethasone phosphate -loaded microcapsules obtained by a double-emulsion method. Int. J. Pharm. 2023, 639, 122971. [Google Scholar] [CrossRef]
- Vochița, G.; Cadinoiu, A.N.; Rată, D.M.; Atanase, L.I.; Popa, M.; Mahdieh, A.; Mihai, C.T.; Stache, A.B.; Moldovan, C.V.; Băcăiţă, E.S.; et al. Comparative In Vitro Study between Biocompatible Chitosan-Based Magnetic Nanocapsules and Liposome Formulations with Potential Application in Anti-Inflammatory Therapy. Int. J. Mol. Sci. 2024, 25, 8454. [Google Scholar] [CrossRef]
- Clinical and Laboratory Standards Institute (CLSI). Methods for Antimicrobial Susceptibility Testing of Anaerobic Bacteria, 9th ed.; CLSI document M07-A8; CLSI: Wayne, PA, USA, 2018. [Google Scholar]
- Humphries, R.M.; Ambler, J.; Mitchell, S.L.; Castanheira, M.; Dingle THindler, J.A.; Koeth, L.; Sei, K. CLSI Methods Development and Standardization Working Group Best Practices for Evaluation of Antimicrobial Susceptibility Tests. J. Clin. Microbiol. 2018, 56, e01934-17. [Google Scholar] [CrossRef] [PubMed]
- Available online: https://www.calculator.net/standard-deviation-calculator.html (accessed on 6 February 2025).
- Available online: https://www.statskingdom.com/180Anova1way.html (accessed on 6 February 2025).
- Pantoja-Castro, M.A.; González-Rodríguez, H. Study by infrared spectroscopy and thermogravimetric analysis of Tannins and Tannic Acid. Rev. Latinoamer. Quím. 2011, 39, 107–112. [Google Scholar]
- Gierszewska-Drużyńska, M.; Ostrowska-Czubenko, J. The effect of ionic crosslinking on thermal properties of hydrogel chitosan membranes. In Progress on Chemistry and Application of Chitin and Its Derivatives; Jaworska, M.M., Ed.; Polish Chitin Society: Łódź, Poland, 2010; pp. 25–32. [Google Scholar]
- Farjadian, F.; Akbarizadeh, A.R.; Tayebi, L. Synthesis of novel reducing agent for formation of metronidazole-capped silver nanoparticle and evaluating antibacterial efficiency in gram-positive and gram-negative bacteria. Heliyon 2020, 6, e04747. [Google Scholar] [CrossRef] [PubMed]
- Danaei, M.; Dehghankhold, M.; Ataei, S.; Hasanzadeh Davarani, F.; Javanmard, R.; Dokhani, A.; Khorasani, S.; Mozafari, M.R. Impact of Particle Size and Polydispersity Index on the Clinical Applications of Lipidic Nanocarrier Systems. Pharmaceutics 2018, 10, 57. [Google Scholar] [CrossRef]
- Zhu, L.; Ouyang, F.; Fu, X.; Wang, Y.; Li, T.; Wen, M.; Zha, G.; Yang, X. Tannic acid modified keratin/sodium alginate/carboxymethyl chitosan biocomposite hydrogels with good mechanical properties and swelling behavior. Sci. Rep. 2024, 14, 12864. [Google Scholar] [CrossRef]
- Ritger, P.L.; Peppas, N.A. A simple equation for description of solute release II. Fickian and anomalous release from swellable devices. J. Control. Rel. 1987, 5, 37–42. [Google Scholar] [CrossRef]
- Ozturk, M.-R.; Popa, M.; Rata, D.M.; Cadinoiu, A.N.; Parfait, F.; Delaite, C.; Atanase, L.I.; Solcan, C.; Daraba, O.M. Drug-Loaded Polymeric Micelles Based on Smart Biocompatible Graft Copolymers with Potential Applications for the Treatment of Glaucoma. Int. J. Mol. Sci. 2022, 23, 9382. [Google Scholar] [CrossRef]
- Cadinoiu, A.N.; Rata, D.M.; Atanase, L.I.; Mihai, C.T.; Bacaita, S.E.; Popa, M. Formulations Based on Drug Loaded Aptamer-Conjugated Liposomes as a Viable Strategy for the Topical Treatment of Basal Cell Carcinoma-In Vitro Tests. Pharmaceutics 2021, 13, 866. [Google Scholar] [CrossRef]
- Matuschek, E.; Copsey-Mawer, S.; Petersson, S.; Åhman, J.; Morris, T.E.; Kahlmeter, G. The European committee on antimicrobial susceptibility testing disc diffusion susceptibility testing method for frequently isolated anaerobic bacteria. Clin. Microbiol. Infect. 2023, 29, e1–e795. [Google Scholar] [CrossRef]
- Reissier, S.; Penven, M.; Guérin, F.; Cattoir, V. Recent Trends in Antimicrobial Resistance among Anaerobic Clinical Isolates. Microorganisms 2023, 11, 1474. [Google Scholar] [CrossRef]
- Álvarez-Pérez, S.; Blanco, J.L.; García, M.E. Clostridium perfringens Type A Isolates of Animal Origin with Decreased Susceptibility to Metronidazole Show Extensive Genetic Diversity. Microb. Drug Resist. 2017, 23, 1053–1058. [Google Scholar] [CrossRef] [PubMed]
- Tally, F.P.; Sullivan, C.E. Metronidazole: In Vitro Activity, Pharmacology and Efficacy in Anaerobic Bacterial Infections. Pharmacother. J. Hum. Pharmacol. Drug Ther. 1981, 1, 28–38. [Google Scholar] [CrossRef] [PubMed]
- Füzi, M. Oxygen-dependent metronidazole-resistance of Clostridium histolyticum. Zentralblatt Für Bakteriol. Mikrobiol. Und Hygiene. 1. Abt. Originale. A Med. Mikrobiol. Infekt. Und Parasitol. 1981, 249, 99–103. [Google Scholar]
- Smith, A. Metronidazole resistance: A hidden epidemic? Br. Dent. J. 2018, 224, 403–404. [Google Scholar] [CrossRef] [PubMed]
- Alnoman, M.; Udompijitkul, P.; Sarker, M.R. Chitosan inhibits enterotoxigenic Clostridium perfringens type A in growth medium and chicken meat. Food Microbiol. 2017, 64, 15–22. [Google Scholar] [CrossRef] [PubMed]
- Xu, H.; Zhang, X.; Li, P.; Luo, Y.; Fu, J.; Gong, L.; Lv, Z.; Guo, Y. Effects of Tannic Acid Supplementation on the Intestinal Health, Immunity, and Antioxidant Function of Broilers Challenged with Necrotic Enteritis. Antioxidants 2023, 12, 1476. [Google Scholar] [CrossRef]
- Xu, H.; Fu, J.; Luo, Y.; Li, P.; Song, B.; Lv, Z.; Guo, Y. Effects of tannic acid on the immunity and intestinal health of broiler chickens with necrotic enteritis infection. J. Anim. Sci. Biotechnol. 2023, 14, 72. [Google Scholar] [CrossRef]

| Samples | CS/TPP (w/w) | Concentration of Chitosan Solutions (%) (w/v) | CS/TA (w/w) |
|---|---|---|---|
| PCTA-1 | 5/3 | 0.5 | 10/1 |
| PCTA-2 | 5/4 | 0.5 | 10/1 |
| PCTA-3 | 1/1 | 0.5 | 10/1 |
| PCTA-4 | 1/1 | 1 | 10/1 |
| PCTA-5 | 1/1 | 0.3 | 10/1 |
| PCTA-6 | 1/1 | 0.3 | 7.5/1 |
| PCTA-7 | 1/1 | 0.3 | 2.5/1 |
| Sample | Z-Average ± SD * (nm) | PDI ± SD * | Zeta Potential ± SD * (mV) |
|---|---|---|---|
| PCTA-1 | 87 ± 5 | 0.59 ± 0.09 | 7.9 ± 0.7 |
| PCTA-2 | 74 ± 11 | 0.51 ± 0.05 | 8.2 ± 0.8 |
| PCTA-3 | 73 ± 9 * | 0.55 ± 0.06 | 8.1 ± 1.1 |
| PCTA-4 | 163 ± 21 * | 0.41 ± 0.03 | 7.9 ± 0.4 |
| PCTA-5 | 74 ± 12 * | 0.48 ± 0.02 | 7.9 ± 0.7 * |
| PCTA-6 | 77 ± 16 | 0.40 ± 0.02 | 8.5 ± 0.3 * |
| PCTA-7 | 79 ± 14 | 0.32 ± 0.01 | 8.8 ± 0.7 * |
| Samples | mg MTZ Loaded/mg Nanoparticles | Entrapment Efficiency (Ee%) |
|---|---|---|
| PCTA1-M | 0.18 ± 0.03 | 21.4 ± 2.5 |
| PCTA2-M | 0.17 ± 0.02 | 20.2 ± 5.8 |
| PCTA3-M | 0.15 ± 0.02 | 17.1 ± 3.6 |
| PCTA4-M | 0.20 ± 0.02 | 25.2 ± 3.2 |
| PCTA5-M | 0.15 ± 0.02 | 17.9 ± 3.2 |
| PCTA6-M | 0.15 ± 0.03 | 18.2 ± 4.7 |
| PCTA7-M | 0.17 ± 0.02 | 21.1 ± 3.7 |
| Sample | n | k × 102 | R2 |
|---|---|---|---|
| PCTA1-M | 0.38 | 17.6 | 0.995 |
| PCTA2-M | 0.43 | 14.1 | 0.999 |
| PCTA3-M | 0.45 | 11.8 | 0.975 |
| PCTA4-M | 0.50 | 11.5 | 0.986 |
| PCTA5-M | 0.44 | 12.7 | 0.996 |
| PCTA6-M | 0.45 | 12.6 | 0.989 |
| PCTA7-M | 0.41 | 11.9 | 0.991 |
| Samples | Loaded MTZ (µg) | Clostridium perfringens (mm) |
|---|---|---|
| Free MTZ (4.5 µg) | - | 26.8 ± 0.2 |
| PCTA3-1(Control) | 0 | 0 |
| PCTA3-M-1 | 11.5 | 32.3 ± 0.3 * |
| PCTA3-2 (Control) | 0 | 0 |
| PCTA3-M-2 | 7 | 30.3 ± 0.3 |
| PCTA3-3 (Control) | 0 | 0 |
| PCTA3-M-3 | 4.5 | 29.7 ± 0.3 |
Disclaimer/Publisher’s Note: The statements, opinions and data contained in all publications are solely those of the individual author(s) and contributor(s) and not of MDPI and/or the editor(s). MDPI and/or the editor(s) disclaim responsibility for any injury to people or property resulting from any ideas, methods, instructions or products referred to in the content. |
© 2025 by the authors. Licensee MDPI, Basel, Switzerland. This article is an open access article distributed under the terms and conditions of the Creative Commons Attribution (CC BY) license (https://creativecommons.org/licenses/by/4.0/).
Share and Cite
Cadinoiu, A.N.; Rata, D.M.; Daraba, O.M.; Atanase, L.I.; Horhogea, C.E.; Chailan, J.-F.; Popa, M.; Carauleanu, A. Metronidazole-Loaded Chitosan Nanoparticles with Antimicrobial Activity Against Clostridium perfringens. Pharmaceutics 2025, 17, 294. https://doi.org/10.3390/pharmaceutics17030294
Cadinoiu AN, Rata DM, Daraba OM, Atanase LI, Horhogea CE, Chailan J-F, Popa M, Carauleanu A. Metronidazole-Loaded Chitosan Nanoparticles with Antimicrobial Activity Against Clostridium perfringens. Pharmaceutics. 2025; 17(3):294. https://doi.org/10.3390/pharmaceutics17030294
Chicago/Turabian StyleCadinoiu, Anca Niculina, Delia Mihaela Rata, Oana Maria Daraba, Leonard Ionut Atanase, Cristina Elena Horhogea, Jean-François Chailan, Marcel Popa, and Alexandru Carauleanu. 2025. "Metronidazole-Loaded Chitosan Nanoparticles with Antimicrobial Activity Against Clostridium perfringens" Pharmaceutics 17, no. 3: 294. https://doi.org/10.3390/pharmaceutics17030294
APA StyleCadinoiu, A. N., Rata, D. M., Daraba, O. M., Atanase, L. I., Horhogea, C. E., Chailan, J.-F., Popa, M., & Carauleanu, A. (2025). Metronidazole-Loaded Chitosan Nanoparticles with Antimicrobial Activity Against Clostridium perfringens. Pharmaceutics, 17(3), 294. https://doi.org/10.3390/pharmaceutics17030294

